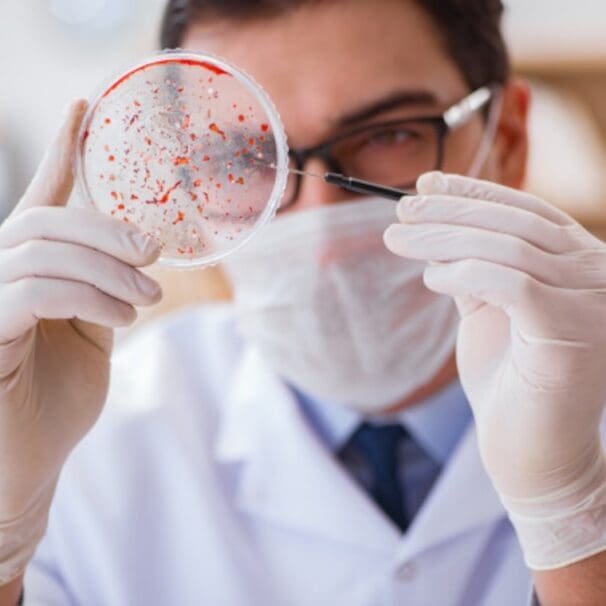

HealthProviders DB is a comprehensive database of healthcare providers, including a complete directory of all Medical Microbiology Physicians.
Pathology Healthcare Taxonomy Code 207ZM0300X
As of today, the following are the total number of Medical Microbiology Physicians nationally, in your State, and near your location.
Select a State below to view the list by State. Additionally, you can narrow the list by city, among other options, from the Filter Panel, which you can open by clicking the vertical ellipses ⋮ in the upper right corner of the app.
Alaska – Alabama – Armed Forces Pacific – Arkansas – American Samoa – Arizona – California – Colorado – Connecticut – District of Columbia – Delaware – Florida – Federated States of Micronesia – Georgia – Guam – Hawaii – Iowa – Idaho – Illinois – Indiana – Kansas – Kentucky – Louisiana – Massachusetts – Maryland – Maine – Marshall Islands – Michigan – Minnesota – Missouri – Northern Mariana Islands – Mississippi – Montana – North Carolina – North Dakota – Nebraska – New Hampshire – New Jersey – New Mexico – Nevada – New York – Ohio – Oklahoma – Oregon – Pennsylvania – Puerto Rico – Palau – Rhode Island – South Carolina – South Dakota – Tennessee – Texas – Utah – Virginia – Virgin Islands – Vermont – Washington – Wisconsin – West Virginia – Wyoming
Medicare & Medicaid Exclusions
The following are the total number of Medical Microbiology Physicians who accept Medicare in your State, the number who have opted out of Medicare, and the total number excluded from participation in Medicare nationwide.
The diagram below shows all the Medical Microbiology Physicians across the country, represented by blue bubbles. The larger the bubble, the greater the concentration of providers in that area. Red bubbles represent Medicare-excluded providers, with the larger bubbles indicating a higher percentage of excluded providers in that region. You can change the bubble size to be based on exclusions from the Size menu.
What do Medical Microbiology Physicians do?
Medical microbiology physicians are specialized pathologists who direct the diagnosis, treatment, and control of infectious diseases caused by bacteria, viruses, fungi, and parasites.
They provide expert consultation on selecting and interpreting lab tests, guiding treatment strategies, managing antibiotic use to prevent resistance, and overseeing diagnostic microbiology laboratories.
Additionally, they play crucial roles in infection prevention, educating colleagues, and conducting clinical research to improve practices and develop new methods for combating infectious agents.
What they do
Diagnosis of Infectious Diseases: They identify microbial pathogens (like viruses, bacteria, fungi, and parasites) in patient samples.
Antimicrobial Stewardship: They advise on and optimize the use of antimicrobial agents to prevent the emergence of drug-resistant organisms.
Infection Prevention: They may direct infection control programs within healthcare organizations.
Consultation: They provide expertise to other healthcare professionals on the selection and interpretation of laboratory tests related to infectious diseases.
Laboratory Oversight: They provide medical, scientific, and administrative direction for diagnostic microbiology laboratories, ensuring accurate and efficient operations.
Research and Education: They conduct or guide clinically relevant research to evaluate test performance and define best practices. They also educate and train future laboratory professionals and colleagues.
Key Activities
Research and Development: Participate in research to develop new diagnostic tests and therapies.
Testing: Oversee and interpret various lab tests, including culturing, staining, microscopy, and molecular tests.
Pathogen Identification: Identify specific microbial agents causing infection.
Treatment Guidance: Advise on appropriate treatment and medication selection.
Antibiotic Resistance Monitoring: Monitor and advise on efforts to minimize the spread of antimicrobial resistance.